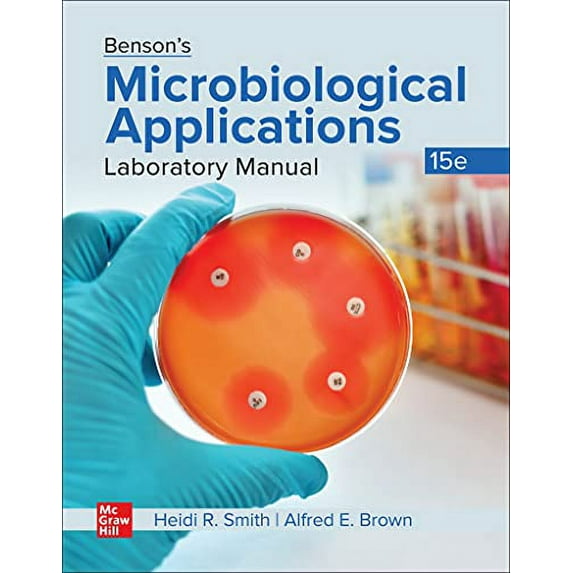
Pre-Owned Loose Leaf for Benson's Microbiological Applications Lab Manual, 9781260425604, 1260425606, Paperback, 15 edition

Pre-Owned Loose Leaf for Benson's Microbiological Applications Lab Manual, 9781260425604, 1260425606, Paperback, 15 edition
Key item features
- Loose Leaf for Benson's Microbiological Applications Lab Manual
- ISBN-10 1260425606, ISBN-13 9781260425604
- Author: Brown; Alfred E.; Smith; Heidi
- 15 edition
- 480 pages
- McGraw Hill
- Binding: Paperback
Specs
- Book formatPaperback
- Pages480
- Edition15 edition
- PublisherMcGraw Hill
- Original languagesEnglish
- Awards wonNone
- Free shipping
Free 30-day returns
How do you want your item?
About this item
Product details
- Loose Leaf for Benson's Microbiological Applications Lab Manual
- ISBN-10 1260425606, ISBN-13 9781260425604
- Author: Brown; Alfred E.; Smith; Heidi
- 15 edition
- 480 pages
- McGraw Hill
- Binding: Paperback
What is Pre-Owned: Good?
What is the Walmart Pre-Owned Program?
Walmart Pre-Owned allows you to find previously owned, well-cared-for items from Walmart’s trusted & performance-managed sellers. Shopping Pre-Owned allows you to bring home the best-quality picks at even lower prices, in addition to extending the life of an item & reducing waste. Find your favorites & shop a range of conditions in every category.
Why Walmart Pre-Owned?
Trusted sellers & quality items
Each Pre-Owned item listed comes from Walmart’s trusted performance-managed sellers, to ensure you get quality items.

Quality you can afford
Save even more on top brands & your most-loved items.

30-day free returns
Don’t love it? Most items offer a 30-day* free return policy, for added peace of mind.
Sustainability
Shopping Pre-Owned helps in extending the life of an item & reducing waste.
Product image for illustration purposes only. The item you receive may vary from the image in minor ways, such as slight differences in appearance, color, and/or design. *Exceptions apply during holiday season, and on certain electronics, collectibles, and jewelry.
Specifications
Book format
Pages
Edition
Publisher
Warranty
Warranty information
Similar items you might like
Based on what customers bought
Pre-Owned Criminal Investigation (MindTap Course List), 9780357511671, 0357511670, Paperback, 12 edition $81.98
2 optionsAvailable in additional 2 options$8198current price $81.98Pre-Owned Criminal Investigation (MindTap Course List), 9780357511671, 0357511670, Paperback, 12 edition
Pre-Owned Loose Leaf for Auditing & Assurance Services, 9781266847103, 1266847103, Paperback, 9 edition $88.49
$8849current price $88.49Pre-Owned Loose Leaf for Auditing & Assurance Services, 9781266847103, 1266847103, Paperback, 9 edition
Pre-Owned Upholstery: A Complete Course Paperback $9.95
2 optionsAvailable in additional 2 options$995current price $9.95Pre-Owned Upholstery: A Complete Course Paperback
Pre-Owned Side by Side (Extra) 2 Activity Workbook with CDs Paperback $19.19 Was $24.51
$1919current price $19.19, Was $24.51$24.51Pre-Owned Side by Side (Extra) 2 Activity Workbook with CDs Paperback
Pre-Owned Essentials of Psychology: Concepts and Applications, Loose-Leaf Version, 9781305964174, 1305964179, Paperback, 5 edition $32.65
2 optionsAvailable in additional 2 options$3265current price $32.65Pre-Owned Essentials of Psychology: Concepts and Applications, Loose-Leaf Version, 9781305964174, 1305964179, Paperback, 5 edition
Pre-Owned Formulating a Differential Diagnosis for the Advanced Practice Provider, 9780826144669, 0826144667, Paperback, Third Edition, New edition $56.50 Was $67.18 20.2 ¢/lb
$5650current price $56.50, Was $67.18$67.1820.2 ¢/lbPre-Owned Formulating a Differential Diagnosis for the Advanced Practice Provider, 9780826144669, 0826144667, Paperback, Third Edition, New edition
Pre-Owned Loose-leaf Version for Genetics: A Conceptual Approach, 9781319308308, 1319308309, Paperback, Seventh edition $142.34
$14234current price $142.34Pre-Owned Loose-leaf Version for Genetics: A Conceptual Approach, 9781319308308, 1319308309, Paperback, Seventh edition
15 out of 5 Stars. 1 reviewsPre-Owned Loose Leaf for Integrated Principles of Zoology, 9781260411140, 1260411141, Paperback, 18 edition $23.64 Was $61.99
$2364current price $23.64, Was $61.99$61.99Pre-Owned Loose Leaf for Integrated Principles of Zoology, 9781260411140, 1260411141, Paperback, 18 edition
Pre-Owned She Comes First (Paperback) 0062174371 9780062174376 $10.19
$1019current price $10.19Pre-Owned She Comes First (Paperback) 0062174371 9780062174376
Pre-Owned The Cell: A Molecular Approach, 9780197583722, 0197583725, Hardcover, 9 edition $99.19
$9919current price $99.19Pre-Owned The Cell: A Molecular Approach, 9780197583722, 0197583725, Hardcover, 9 edition
Pre-Owned Technology in Action, Complete (Paperback) 0135435196 9780135435199 $21.19
3 optionsAvailable in additional 3 options$2119current price $21.19Pre-Owned Technology in Action, Complete (Paperback) 0135435196 9780135435199
Pre-Owned Introduction to Manufacturing Processes Paperback $88.99
$8899current price $88.99Pre-Owned Introduction to Manufacturing Processes Paperback
Pre-Owned Lab Manual Experiments in General Chemistry (Paperback) by Rupert Wentworth, Barbara Munk $109.87
2 optionsAvailable in additional 2 options$10987current price $109.87Pre-Owned Lab Manual Experiments in General Chemistry (Paperback) by Rupert Wentworth, Barbara Munk
Pre-Owned Acsm's Introduction to Exercise Science (Paperback) 1975209133 9781975209131 $57.71 Was $67.78
3 optionsAvailable in additional 3 options$5771current price $57.71, Was $67.78$67.78Pre-Owned Acsm's Introduction to Exercise Science (Paperback) 1975209133 9781975209131
Pre-Owned Loose Leaf for Biology: The Essentials, 9781264388950, 1264388950, Paperback, 4 edition $75.73 24.3 ¢/lb
$7573current price $75.7324.3 ¢/lbPre-Owned Loose Leaf for Biology: The Essentials, 9781264388950, 1264388950, Paperback, 4 edition
Pre-Owned The Feldenkrais Method: Learning Through Movement, 9781912085699, 1912085690, Paperback, 1 edition $41.24
$4124current price $41.24Pre-Owned The Feldenkrais Method: Learning Through Movement, 9781912085699, 1912085690, Paperback, 1 edition
Pre-Owned MKTG, 9780357929216, 0357929217, Paperback, 14 edition $58.12 Was $73.49
$5812current price $58.12, Was $73.49$73.49Pre-Owned MKTG, 9780357929216, 0357929217, Paperback, 14 edition
Pre-Owned The EFT Manual (Paperback) 1604150300 9781604150308 $7.21
$721current price $7.21Pre-Owned The EFT Manual (Paperback) 1604150300 9781604150308
Pre-Owned Sonography Tech QuickStudy Laminated Reference Guide, 9781423208952, 1423208951, Paperback, First Edition edition $5.55 Was $10.53
$555current price $5.55, Was $10.53$10.53Pre-Owned Sonography Tech QuickStudy Laminated Reference Guide, 9781423208952, 1423208951, Paperback, First Edition edition
Pre-Owned Acsm's Metabolic Calculations Handbook (Paperback) 0781742382 9780781742382 $17.75
3 optionsAvailable in additional 3 options$1775current price $17.75Pre-Owned Acsm's Metabolic Calculations Handbook (Paperback) 0781742382 9780781742382
